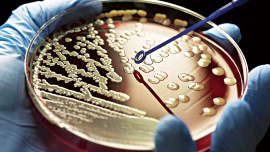
plos-genetics.jpg
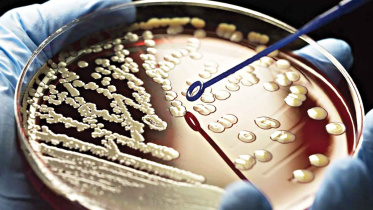
typhoid-causing-bacteria.jpg

Pioneering global delivery of childhood cancer medications
15 February 2025, 18:00 PM
Research
Repeat MRI scans for pituitary microadenomas may be unnecessary: study suggests
13 May 2023, 18:00 PM
Research
Magic mushroom shows promise as depression treatment: Study
3 November 2022, 07:47 AM
Research
Typhoid-causing bacteria have become increasingly resistant to essential antibiotics and have spread widely over past 30 years
25 June 2022, 18:00 PM
Research
A person’s height impacts their risk of multiple diseases
11 June 2022, 18:00 PM
Research
Salmonella vaccine for poultry contributed to rise of antibiotic-resistant bacteria
4 June 2022, 18:00 PM
Research
WorldFish-invented ‘G-3’ Rohu grows about 30 per cent more than conventional one
4 June 2022, 18:00 PM
Research
Did you know? / While the fetal clock develops, mom’s behaviour tells the time
28 May 2022, 18:00 PM
Research
The threat of untreatable gonorrhoea could be tackled using an existing meningitis vaccine
23 April 2022, 18:00 PM
Research
Human microbiome research excludes developing world
26 February 2022, 18:00 PM
Research
Pioneering global delivery of childhood cancer medications
The World Health Organisation (WHO) and St. Jude Children’s Research Hospital have launched the distribution of essential childhood cancer medicines in Mongolia and Uzbekistan as part of the Global Platform for Access to Childhood Cancer Medicines.
15 February 2025, 18:00 PM
Repeat MRI scans for pituitary microadenomas may be unnecessary: study suggests
Autopsy and imaging studies have shown that around 10% of adults may have pituitary microadenomas, which are small growths in the pituitary gland. These growths are often found incidentally during an MRI scan and are usually less than 10mm in size.
13 May 2023, 18:00 PM
Magic mushroom shows promise as depression treatment: Study
The main psychoactive ingredient found in magic mushrooms can significantly reduce symptoms of difficult-to-treat depression, data from the largest clinical trial ever to test the keenly-watched compound has found.
3 November 2022, 07:47 AM
Typhoid-causing bacteria have become increasingly resistant to essential antibiotics and have spread widely over past 30 years
According to a study in The Lancet Microbe, Typhoid-causing bacteria are becoming resistant to necessary antibiotics.
25 June 2022, 18:00 PM
A person’s height impacts their risk of multiple diseases
Tall stature increases the risk of peripheral neuropathy and skin and bone infections. According to a new study performed at the Rocky Mountain Regional VA Medical Center in the U.S., a person’s height raises their risk for a variety of diseases.
11 June 2022, 18:00 PM
Salmonella vaccine for poultry contributed to rise of antibiotic-resistant bacteria
According to a new study recently published in the journal PLOS Genetics, resistant strains in Brazil find that exported poultry rarely causes disease in the UK. In addition, an investigation into the evolution of Salmonella bacteria infecting Brazilian poultry shows that the introduction of a Salmonella vaccine, combined with increasing antibiotic usage by Brazilian farmers, has led to the rise of antibiotic-resistant strains that are less likely to cause human disease.
4 June 2022, 18:00 PM
WorldFish-invented ‘G-3’ Rohu grows about 30 per cent more than conventional one
Preliminary results from an experimental farm have shown that the ‘third generation’ or G-3 Rohu invented by WorldFish grows about 30 per cent more than the conventional Rohu fish - says a press release.
4 June 2022, 18:00 PM
While the fetal clock develops, mom’s behaviour tells the time
During foetal development, before the biological clock starts ticking on its own, genes respond to rhythmic behaviour in the mother.
28 May 2022, 18:00 PM
The threat of untreatable gonorrhoea could be tackled using an existing meningitis vaccine
According to findings from a study published in The Lancet Infectious Diseases journal, meningitis vaccines could help improve protection against gonorrhoea amid rising cases globally and increase bacterial resistance to drugs used to treat the infection.
23 April 2022, 18:00 PM
Human microbiome research excludes developing world
The bacteria in our bodies have been linked to colon cancer, ulcers, and cognitive diseases like Alzheimer’s. However, a study published in
26 February 2022, 18:00 PM
Quantifying the global impact of antimicrobial resistance
Antimicrobial resistance kills millions of people every year. Noticeably, bacterial antimicrobial resistance (AMR) is a growing cause of morbidity and mortality. The researchers have now estimated the number of AMR-related deaths globally.
12 February 2022, 18:00 PM
Harmful bacteria, fungi found in buffalo yoghurt
Researchers in Chattogram have found harmful bacterial and fungal presence in various brands of buffalo yoghurt in different districts of the country. Most cow yoghurt from popular brands, however, have been found to be safe with the expected nutrition level.
13 January 2022, 18:00 PM
Conformal radiotherapy & medical physics
Cancer, a leading cause of death globally. Radiotherapy is essential in managing the cancer patient alongside chemotherapy or surgery for cure or palliation. About 60% of patients receive radiotherapy as definitive, adjuvant or palliative to surgery or chemotherapy each year. Radiotherapy aims to deliver a precise dose of radiation to the defined tumour volume without causing damage to the surrounding normal tissues.
8 January 2022, 18:00 PM
Innovative cancer therapy shows early promise
Cancer treatment involves early awareness, early prevention, screening/early detection and early treatment. The bacterial defensive mechanism is a renewed interest in cell gene editing simplified by Clustered Regularly Interspaced Short Palindromic Repeats (CRISPR) technology.
13 November 2021, 18:00 PM
Genetic study of heart defects and autism finds new causative genes
Researchers identified almost two dozen genes that contribute to heart defects by studying genetic data from people born with congenital heart disease or autism.
6 November 2021, 18:00 PM
Merck to let other manufacturers make its Covid pill
Pharmaceutical company Merck agreed to allow other drug makers to produce its COVID-19 pill, in a move aimed at helping millions of people in poorer countries get access to the potentially life-saving drug, a United Nations-backed public health organization said on Wednesday.
27 October 2021, 15:46 PM
WHO’s revised Essential Medicines Lists highlight diabetes and cancer meds
World Health Organisation (WHO) recently updated its Model Lists of Essential Medicines and Essential Medicines for Children, including new cancer treatments and diabetes medicines.
16 October 2021, 18:00 PM
Call for experts to join Scientific Advisory Group for the Origins of Novel Pathogens
The World Health Organisation (WHO) issued an open call for experts to serve as members of the new WHO Scientific Advisory Group for the Origins of Novel Pathogens (SAGO).
21 August 2021, 18:00 PM
WHO seeks 'best minds' to probe new pathogens that jump from animals to humans
The World Health Organization (WHO) said on Friday it was looking for the greatest scientific minds to advise on investigations into new high-threat pathogens that jump from animals to humans and could spark the next pandemic.
20 August 2021, 15:48 PM
Researchers trial magnetic ‘lockjaw’ against obesity
New Zealand researchers have created a weight-loss device that uses magnets to clamp a patient's jaw together -- hailing it as a new tool against obesity despite critics likening it to an instrument of medieval torture.
3 July 2021, 18:00 PM